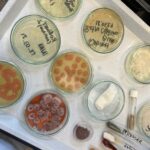

Ultimele articole

Cătălin Doscaș
Reporter și redactor-șef Buletin de București. Lucrează în mass-media de la vârsta de 15 ani, când a publicat primele articole în presa locală din Tecuci. În București a lucrat în redacții radio ca reporter, redactor și prezentator (StudentFM, NaționalFM, Radio Total, Smart FM), unde a acoperit domeniile politic, economic, social și externe. Ulterior, a fost editor-coordonator al postului Realitatea FM. Experiența în jurnalismul online a dobândit-o la portalul B365.ro, unde a fost editor. În 2012 s-a angajat în televiziune. La Realitatea TV a fost, pe rând, reporter la secția Social, reporter special la emisiunea de reportaje și anchete „Reporterii Realității”, dar și editor al jurnalelor de știri. Ulterior, a făcut parte din secția de Investigații de la Digi24 și a lucrat la campania „România furată”. A revenit în presa scrisă în 2017, ca reporter special, în cadrul unui proiect de repoziționare a tabloidului Libertatea în cotidian generalist. Este jurnalist Buletin de București din 2019.